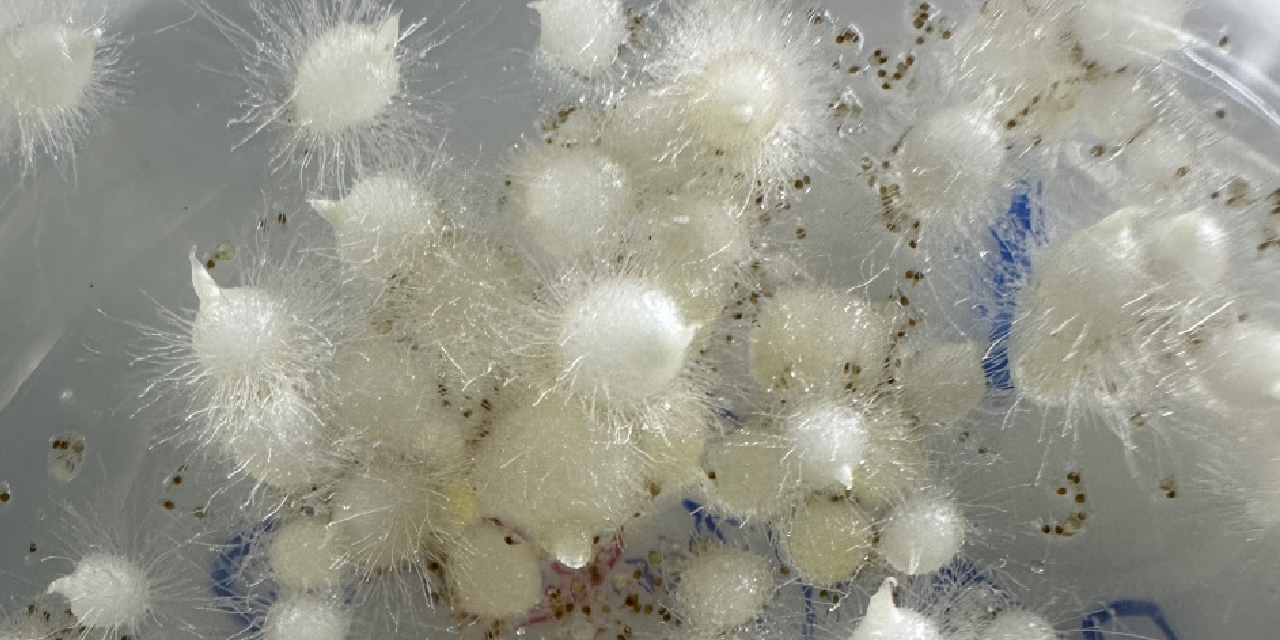
likya-orkidesi-ilk-kez-tohumdan-uretildi.jpg

Salep uğruna yok oluyordu: Likya orkidesi ilk kez tohumdan üretildi! Gerçek salep nasıl anlaşılır?

Nesli tehlike altındaki Likya orkidesi (Ophrys lycia) ilk kez tohumdan üretildi. Antalya’nın Kaş ilçesinde yürütülen çalışma, salep üretimi, orkide faydaları, salep tüketimi ve doğadan toplama yasakları gibi kritik başlıkları yeniden gündeme taşıdı.
Antalya’nın Kaş ilçesine bağlı üç köyde yayılış gösteren Likya orkidesi (Ophrys lycia), sınırlı yaşam alanı ve yoğun insan baskısı nedeniyle yok olma sınırına gelmiş endemik türler arasında yer alıyor. Uluslararası Doğayı Koruma Birliği (IUCN) tarafından “kritik tehlikede” kategorisinde değerlendirilen bu tür, ilk kez kontrollü şekilde tohumdan üretilerek bilimsel bir başarıya imza atıldı.
Yaklaşık 30–40 santimetreye kadar boylanabilen bitki, nisan ayında çiçek açıyor ve aynı gövdede 7–8 çiçeğe kadar ulaşabiliyor. Pembe ve menekşe tonlarındaki çiçekleriyle dikkat çeken orkidenin, toprak altında iki yumrusu bulunuyor. Bu yumrular, Türkiye’de kış aylarının vazgeçilmezi olan salebin ana hammaddesini oluşturuyor.
SALEP ÜRETİMİ ORKİDEYİ NASIL TEHDİT EDİYOR?
Akdeniz Koruma Derneği ve Ege Üniversitesi iş birliğinde yürütülen proje kapsamında, orkidenin doğadan kaçak toplanmasının önüne geçilmesi hedefleniyor. Proje yürütücüsü Nejdet Bozkurt, son 20 yılda türün sayısının binlerden 200’e kadar düştüğünü belirtiyor.
Türkiye’de her yıl yaklaşık 100 milyon orkide kökünün salep üretimi için doğadan söküldüğü ifade edilirken, bu durum sadece bitkiyi değil ekosistemi de tehdit ediyor. Turizm, yapılaşma ve tarımda kullanılan kimyasallar da tür üzerindeki baskıyı artırıyor.

SALEP NEDİR, NASIL YAPILIR VE NEDEN BU KADAR DEĞERLİ?
Orkide yumrularından elde edilen salep, özellikle kış aylarında sıcak içecek olarak tüketiliyor. Aynı zamanda dondurma üretiminde kıvam artırıcı olarak da kullanılıyor. Bu geleneksel ürünün üretim süreci doğrudan doğadaki orkide popülasyonuna bağlı olduğu için sürdürülebilirlik sorunu yaratıyor.
Biliyor muydunuz?
Bir fincan gerçek salep üretmek için doğadan onlarca orkide yumrusunun sökülmesi gerekiyor. Bu nedenle birçok ülkede yabani orkide türlerinin toplanması tamamen yasaklanmış durumda.

SALEBİN FAYDALARI, TÜKETİMİ VE DİKKAT EDİLMESİ GEREKENLER
Salep, bağışıklık sistemini destekleyen, sindirimi kolaylaştıran ve özellikle soğuk algınlığı dönemlerinde tercih edilen doğal bir içecek olarak biliniyor. İçeriğindeki glukomannan sayesinde tokluk hissi sağladığı ve mideyi rahatlattığı ifade ediliyor. Aşırı tüketimi sindirim sorunlarına yol açabiliyor.
Uzmanlara göre salep tüketimi günde 1 fincanı geçmemeli. Özellikle hazır ürünlerde nişasta oranının yüksek olması nedeniyle “gerçek salep” ile “aromalı içecek” ayrımına dikkat edilmesi gerekiyor.

SALEP NASIL SEÇİLİR?
Gerçek salep seçerken kokusu, kıvamı ve içeriği belirleyici oluyor. Saf salep, pişirildiğinde yoğun kıvam alır ve doğal bir orkide aroması yayar. Toz halinde satılan ürünlerde katkı maddesi olup olmadığı mutlaka kontrol edilmeli.
Salep hazırlanırken yüksek ateşte uzun süre kaynatılması, hem besin değerini düşürür hem de kararmaya neden olabilir. Bu nedenle düşük ısıda, sürekli karıştırarak pişirilmesi öneriliyor.

DÜNYADA ORKİDE TOPLAMAK NEDEN YASAK?
Yabani orkide türleri, Avrupa başta olmak üzere birçok ülkede koruma altında bulunuyor. Özellikle Uluslararası Doğayı Koruma Birliği kriterlerine göre kritik seviyede olan türlerin doğadan toplanması ciddi yaptırımlara tabi.
Türkiye’de de orkide sökümü izne bağlı ve kontrolsüz toplama yasak. Kaçak hasat faaliyetleri hala büyük bir sorun olmaya devam ediyor.

TOHUMDAN ÜRETİM NEDEN KRİTİK BİR ADIM?
Projede ilk kez uygulanan tohumdan üretim yöntemi, orkidenin doğadan sökülmeden çoğaltılmasını mümkün kılıyor. Laboratuvar ortamında yaklaşık 400 gün süren süreç sonunda elde edilen fidelerin 4 aydır doğada yaşamını sürdürdüğü belirtiliyor.
Elde edilen tohumlar aynı zamanda ulusal tohum bankasına gönderilerek genetik mirasın korunması da sağlandı. Uzmanlar, bu yöntemin yaygınlaşması halinde hem salep üretiminin sürdürülebilir hale gelebileceğini hem de doğadaki orkide popülasyonunun korunabileceğini vurguluyor.

ORKİDE SADECE BİR BİTKİ DEĞİL, KÜLTÜREL MİRAS
Likya orkidesi yalnızca biyolojik çeşitliliğin bir parçası değil, aynı zamanda Türkiye’nin gastronomi ve kültür mirasının da önemli bir unsuru. Bu mirasın korunabilmesi için hem üretim hem de tüketim alışkanlıklarının yeniden gözden geçirilmesi gerekiyor.
Kaynak:AA

Türkçe karakter kullanılmayan ve büyük harflerle yazılmış yorumlar onaylanmamaktadır.